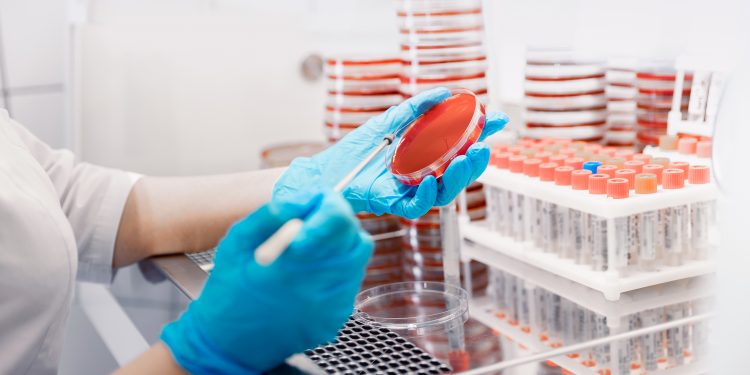

Antimicrobial stewardship is an important mission for healthcare, a mission built on the “it takes a whole village” idea. Read on to see the big picture and how to contribute to the success of this global endeavor.
The Miracle Drug
Penicillin was discovered by Alexander Fleming in 1928. It was further developed for medicinal use by Drs. Howard Florey and Ernst Chain of Oxford University, just in time for treating soldiers in World War II. Penicillin was quickly dubbed a “miracle drug” and is considered one of the greatest contributions to health in the 20th century.
Penicillin bolstered human life expectancy by 27 years and allowed people more normal lives without the perpetual worry of common infections such as strep throat, pneumonia or sexually transmitted infections.
Undoubtedly, antibiotics like penicillin revolutionized healthcare and continue to save lives. However, with the near-indiscriminate use of the miracle drug—understandably fueled by vivid and morbid memories of overwhelming infections—antibiotic resistance followed on the coattails of overuse, complacency and misuse. This resistance threatened to diminish the progress made in the fight to control infectious diseases.
There is no single factor to blame for the development and expansion of antibiotic resistance. Rather, it was a combination of medical advances:
- Overuse and misuse of antibiotics
- A tremendous increase in the size of immunocompromised populations
- A higher frequency of invasive medical procedures, longer hospital stays and more ICU days
- Individuals with chronic debilitating conditions living longer
Science showed that resistance to antimicrobials was inevitable, but there are measures to slow this resistance, ideally to a more manageable pace. At the core of this endeavor is an essential need to understand and respect these drugs.
Antibiotic Resistance
An antibiotic is a selective poison, targeting bacterial cells and killing the pathogen while avoiding or minimizing damage to the human cells and human host. Different types of antibiotics affect different bacteria and act in different ways. For example, an antibiotic might inhibit the ability of the bacterium to turn glucose into energy, or by attacking its cell wall, as penicillin does. Penicillin attaches to a cell’s wall and destroys a key part of it, which causes the cytoplasm to spill out, killing the bacterium.
The antibiotic does not technically cause resistance but rather allows it to happen. This is an evolutionary process, and sometimes evolution is relatively rapid. Any population of microbes naturally includes variants with unique traits; these might include an ability to withstand an attack of the drug. (We learned that with COVID-19.)
When a patient takes an antibiotic, the drug kills defenseless bacteria and leaves behind those that resisted it. This is called “selecting.” The surviving bacteria then multiply, increasing their numbers a millionfold in a day, and the variant becomes the predominant microbe.
A patient can develop a drug-resistant infection, either by exposure to an already resistant microbe, or by creating a resistant microbe in their body once undergoing antibiotic treatment.
Pathogens resist antibiotics by interfering with the drug’s mechanism of action. Bacteria that survive an antibiotic assault can make changes in their own structure and pass the information to their “offspring.” Bacteria can also transfer genes by swapping DNA packets known as “plasmids.” In the healthcare environment where bacteria are challenged by antibiotics, genes that confer resistance become available to bacterial populations and create a perfect storm for resistance.
Stewardship
Resistance spreads fast, necessitating a plan to slow the pace, because there is no going back. The plan is a series of programs known as “antimicrobial stewardship.” Since these programs are used to control a variety of microbes (e.g., bacteria, yeasts, microscopic fungi) from developing resistance, “antimicrobial” is a preferred term (rather than antibiotic) to be more inclusive. “Stewardship” is a fitting word, as it implies responsibility in overseeing and protecting something worth caring for and preserving. The term also indicates positivity and comprehensive understanding of the microbes, the drugs, human behaviors, and alternatives to infection prevention.
The core elements of an antimicrobial stewardship program are accomplished by the entire community of health professionals and directed through healthcare organizations. Here’s the outline:
- Prescribing and using antibiotics appropriately and only when necessary (for both humans and animals) by ensuring:
- Antibiotics are prescribed only for confirmed bacterial infections and only when truly needed
- The appropriate antibiotic is prescribed at the proper dose and for the proper duration
- That prescribed antibiotics are used until the full antibiotic course is finished
- Preventing infectious disease by:
- Washing hands
- Avoiding cross-contamination with appropriate personal protective equipment (PPE) when contact is unavoidable
- Keeping current with vaccinations
- Improving hygiene and sanitation
- Promoting and monitoring infection prevention and control measures via surveillance and reporting to combat the misuse of antibiotics.
Prior Authorization
Some facilities restrict the use of certain antibiotics based on the spectrum of activity, cost or associated toxicities. Furthermore, some facilities ensure that intended use is reviewed by an antibiotic expert before therapy is initiated. This intervention requires availability of expertise in antibiotic use and infectious diseases, and its authorization needs to be completed in a timely manner. This function is managed by clinical pharmacists who can communicate directly with prescribing physicians.
Know Your Role
Nurses and technicians do not prescribe antimicrobial drugs, but they play a role in stewardship. Nurses can assure that cultures are performed before starting antibiotics. They also collect specimens for culture and therefore contribute to an accurate diagnosis. In addition, nurses review medications as part of their routine duties and can prompt discussions of antibiotic treatment, indication and duration.
Antibiotic “time-outs” are another key area in being a good steward. Antibiotics are often started empirically in hospitalized patients while diagnostic information is being obtained. However, providers often do not revisit the selection of the antibiotic after more clinical and laboratory data (including culture results) become available.
An antibiotic “time out” prompts a reassessment of the continuing need and choice of antibiotics when the clinical picture is more clear and more diagnostic information is available. All clinicians should perform a review of antibiotics 48 hours after they are initiated and answer these key questions:
- Does this patient have an infection that will respond to antibiotics? If so, is the patient on the right antibiotic(s), dosage and route of administration?
- Can a more targeted antibiotic be used to treat the infection (de-escalate)?
- How long should the patient receive the antibiotic(s)?
Patient Education
Every facility or healthcare organization should have an antimicrobial stewardship program and should provide regular updates on antibiotic prescribing, antibiotic resistance, and infectious-disease management that address both national and local issues. Pay attention to these updates and any directives that include your role.
Nurses and pharmacists are responsible for educating patients and family members about the importance of the drug in treating the patient’s infection and the details of administration that will ensure effectiveness. Remind them not to save unused antibiotics for another time when they feel sick. Emphasize the importance of compliance and communication with their prescribing clinician if side effects threaten that compliance with the full course of the drug. Be sure to emphasize that antibiotics do not work on viruses like the common cold.
Please teach and train your family on these important matters, too. It takes a whole village to manage the challenge of antibiotic resistance.